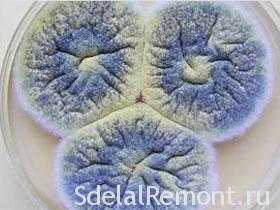

Плесень на стенах. Как вывести плесень и грибок со стены в квартире?
 Плесень и домовой грибок — частые, но не особенно учтивые гости в наших квартирах. Соседствовать с ними опасно для здоровья, а вывести непросто. Стоит устранить один очаг, как рядом через несколько дней обнаруживается новое пятно. Отчаявшись избавиться от грибка на стенах, хозяева задумываются о смене квартиры. Но где гарантия, что на новом месте жительства проблема вновь не заявит о себе?
Плесень и домовой грибок — частые, но не особенно учтивые гости в наших квартирах. Соседствовать с ними опасно для здоровья, а вывести непросто. Стоит устранить один очаг, как рядом через несколько дней обнаруживается новое пятно. Отчаявшись избавиться от грибка на стенах, хозяева задумываются о смене квартиры. Но где гарантия, что на новом месте жительства проблема вновь не заявит о себе?
Откуда берутся грибок и плесень на стенах квартиры и как с ними бороться
В Библии плесень именуется не иначе как небесным проклятием, перед которым бессильна воля царя и судии. Когда хозяева пораженных домов обращались к пророкам за советом, как вывести или временно убрать грибок со стен, рекомендации были однозначны: от плесени очищает только пламя. В наше время до крайних мер, к счастью, не доходит, поскольку сжечь потребовалось бы едва ли не половину жилищного фонда России.
Народная мудрость знает множество способов, как бороться с плесенью на стенах в квартире подручными средствами — с помощью раствора соды, уксуса, бензина, перекиси или спирта. Однако симптоматические меры не дают обнадеживающих результатов до тех пор, пока в помещениях царит сырость, создающая благодатные условия для развития грибковой микрофлоры.
Как наладить нормальный воздухообмен?
Повышенная влажность в помещении наблюдается на фоне нехватки воздухоомена и застоя отработанных воздушных масс. Недостаточная циркуляция может быть спровоцирована четырьмя разными причинами:
- Герметизация помещения в результате установки энергосберегающих окон в домах старой застройки и установка окон ПВХ в новых зданиях. При отсутствии проветривания металлопластиковые профили полностью закрывают доступ притоку воздушных масс. Из-за недостаточного притока свежего воздуха в помещении скапливается избыточная влажность. Появление плесени в этом случае неминуемо! Если же грибок облюбовал только ванную, возможно, дверь закрывается слишком плотно. И снова организуется благодатная для плесени среда.
- Плохая работа вытяжки. Обмен веществ между живыми огранизмами и окружающей средой сопровождается поглощением кислорода и эмиссией углекислого газа и водного пара. В норме отбработанный воздух удаляется из помещений через вытяжные отверстия в санузлах и на кухне. Состояние системы вытяжной вентиляции проверяется при широко распахнутом окне двумя способами. При наличии тяги пламя свечи, поднесенной к вытяжному отверстию, клонится внутрь шахты, а листок бумаги пристает к решетке. В случае слабой работы вытяжки часто помогает основательная прочистка шахт от многолетних наслоений пыли; если же тяга по-прежнему отсутствует, необходимо известить об этом коммунальные службы.
- Ошибки при проектировании вентиляционных шахт. В домах с дисфункционалными системами вытяжки плесень на стенах проступает уже в течение первых дней со дня сдачи в эксплуатацию. Проблему отчасти решает установка блока принудительной вытяжной вентиляции, но для получения долгосрочного эффекта потребуется серьезный ремонт.
- Сырой подвал или протекающая кровля — верные спутники плесени, досаждающей жителям первых и последних этажей. Для верхнего уровня также характерно ослабление тяги в вентиляционных шахтах из-за неудачного размещения чердака, преграждающего путь подъема воздушных масс. В таком случае ответом на вопрос, как вывести докучливую плесень со стены в квартире, станет монтаж вентиляционных коробов в чердачном помещении.
Приточный клапан «Домвент» – спасение от плесени раз и навсегда!
Регулярное проветривание в зимнее время и ночью невозможно, поэтому не помешает иметь в виду и другие способы поддержки нормальной кратности воздухообмена. Приточные клапаны «Домвент» подскажут вам, как гарантированно избавиться от плесени на стенах в квартире и восполнить недостаток свежего воздуха, не выстудив ни одной комнаты.
В стене делается отверстие для клапана над батареей центрального отопления, свежий воздух дует на радиатор, и таким образом обеспечивается быстрое подогревание воздушных масс до комфортной температуры за счет теплового излучения радиатора. При этом вы не только изведете грибок на стенах в квартире, но и забудете о духоте, пыли, шуме и неприятных запахах с улицы.

Для борьбы с грибком в ванной рекомендуется установить переточную решетку «Двервент», которая восстановит сообщение замкнутого помещения с другими комнатами, защитит от шума и устранит избыток влажности за счет привлечения более сухих воздушных масс.
Вопросы и заявки принимаются по тел. 8–800–100–39–43.
Наши клапаны можно приобрести более чем в 100 городах. Узнайте, где купить Домвент в вашем городе!
Рассчитайте стоимость заказа с установкой!
Калькулятор
Чем опасна черная плесень в доме для организма человека и как от нее избавиться
Вы собираетесь отрезать хлеб и видите бархатные пятна черного цвета, образованные размножившейся плесенью? Или внезапно стали страдать аллергией, хотя раньше ничего подобного за собой не замечали?
Виной всему черный плесневелый гриб, с которым время от времени приходится сталкиваться в собственном доме или в квартире. Согласитесь, не слишком приятно лицезреть черные заросли плесени на продуктах, о существовании которых по каким-либо причинам забыли, или на стенах в ванной, или чего еще хуже — на обоях в детской.
Мы поможем вам справиться с таким нежелательным соседом. Хотя уничтожить его не так-то просто, но и мириться с появлением нельзя. Чтобы найти пути избавления от такой напасти, в этой статье поговорим о том, чем опасна черная плесень в доме, какие ее виды могут селиться в помещениях и какие варианты избавления от нее можно использовать в домашних условиях.
В помощь при борьбе с этим ужасным врагом мы также подобрали наглядные видеопособия по уничтожению грибка и советы по предотвращению его появления.
Содержание статьи:
Виды черного плесневого налета
Если специально не приглядываться, может показаться, что черная плесень – это всего лишь проступившая грязь, от которой можно легко избавится. Но это не так.
Черный плесневой налет – внешнее проявление колонии микроскопических грибов. Более того, эти колонии могут образовывать грибы разного вида. Чаще всего в наших домах встречаются разновидности, перечисленные ниже.
Галерея изображений
Фото из

Появление черной плесени в загородном доме или квартире – опасная ситуация, грозящая почти катастрофическими последствиями

Строительным конструкциям и отделке черная плесень грозит существенной потерей несущей способности, а нередко и полным разрушением. Человеку она угрожает аллергией и астмой

Плесневый грибок распространяется с удивительной скоростью: за пару месяцев при благоприятных для него условиях он может полностью охватить помещение

Благоприятные условия для распространения черной плесени создаются в ванной комнате и на кухне: в помещениях с нестабильной влажностью и температурой. Особенно подвержены помещения с плохо работающей вентиляцией

Даже в помещениях с хорошо отлаженной и стабильно работающей вентиляцией нельзя расслабляться. Грибок может появиться за плинтусом, особенно, если он пластиковый

Черная плесень, поразившая перегородку, быстро “захватывает” и смежное с ванной или кухней помещение

Поражать грибок может практически все: конструкции из бетона, древесины, детали из металла, связующие цементные и клеевые составы

В многоэтажных домах черная плесень может появиться благодаря соседям, регулярно подтапливающим квартиру сверху или не борющимися с ней с любой стороны
Последствия появления черной плесени
Разрушение строительных конструкций
Распространение черной плесени
Поверженная плесенью стена в ванной
Места расселения грибковых колоний
Переход плесени в смежное помещение
Плесень на связующем составе
Возникновение очагов плесени на потолке
Грибок #1 — Аспергилл черный
Аспергилл черный (Aspergillus niger) – это сапрофит, который облюбовал для себя помещения с повышенной влажностью: кухни, ванные комнаты, туалеты или совмещенные санузлы, бассейны.
Колонии этого грибка нередко образуются в увлажнителях воздуха, и даже в кондиционерах.
Часто этой черной плесенью покрываются отсыревшие потолки и стены, обложки старых книг, вазоны для комнатных растений. Излюбленное место появления колонии Aspergillus niger – и санузлах.

Вот так мило и симпатично может выглядеть под микроскопом плесень, которая способна лишить человека не только здоровья, но и самой жизни
На фотографии этот грибок выглядит вполне симпатично, но его присутствие совсем не безобидно.
Даже от незначительного движения воздуха споры этого паразита распространяются по всему помещению, проникают в дыхательные пути людей и домашних животных, оседают на продуктах питания, поселяются в наших вещах.
Благодаря им могут возникнуть совсем небезобидные заболевания:
- менингит;
- миоардит;
- бронхиальная астма или даже пневмония;
- ринит.
Присутствие спор этого грибка может стать причиной образования папиллом и даже клеток рака.
Если человеку доведётся вдохнуть сразу большое количество спор, у него может развиться интоксикация организма. При ослабленном иммунитете, что не редкость в наше время, возникает опасность летального исхода.
Именно Aspergillus niger может стать причиной аспергиллемы легких. Летучие споры грибка способны легко проникнуть через носоглотку в трахею, а затем поразить бронхи, альвеолы и бронхиолы. Закрепившись, они начинают бурно развиваться.
Токсины, выделяемые колонией, способствуют образованию очагов некроза. Как следствие, паренхиматозная ткань легких прекращает функционировать, наступает удушье и смерть.
Грибок #2 — Аспергилл дымящий
Особенностью этой плесени является то, что она стойко переносит повышение температуры окружающей среды от 12 и вплоть до 53 градусов.
Споры грибов Аспергилл дымящий (Aspergillus fumigates) очень маленькие: всего 2-3,5 мкм, поэтому они легко проникают в легкие животных и людей. Здоровые люди могут без последствий вдыхать несколько сотен спор такого грибка.
Но у человека со слабой иммунной системой опасность аспергиллеза многократно возрастает.

Эти колонии, изолированные в чашечке Петри и окруженные зеленоватым сиянием, – очень опасный враг, которому не место в наших жилищах
Когда вблизи стационаров и клиник, где могут находиться больные со сниженным иммунитетом, проводятся ремонтные работы, риск инфицирования пациентов резко повышается.
В таких ситуациях считается необходимым проводить мониторинг воздуха для выявления случаев высокой концентрации болезнетворных спор.
Чаще всего Aspergillus fumigates поражает фрукты и овощи, которые имеют механические повреждения.
Если грибки поразили зерна, их которого впоследствии выпекаются хлебобулочные изделия, то на выпечке довольно быстро образуются черные пушистые пятнышки или плесневый налет.
Дымящийся Аспергилл опасен тем, что токсины, сопровождающие его жизнедеятельность, являются аллергенами. Они способны разрушать эритроциты, входящие в состав крови. Кроме того, токсины этого грибка могут подавлять выработку иммунитета.
Грибок #3 — Альтернария альтерната
Ещё одной разновидностью спорообразующих плесневых грибов является Альтернария альтерната (Alternaria tenuis).
Внешний вид колоний этого гриба зависит от той питательной среды, на которой они образуются. Чаще всего это темно-серые, практически черные, пятна. Но они могут иметь и зеленовато-оливковый оттенок.
Обитает такой гриб на отмирающей части растения. Его колонии можно встретить на осенних листьях, перезревших плодах и даже просто на поверхности почвы.
Эта плесень может приживаться на продуктах питания, в том числе, например, на свинине, а также на текстильных изделиях. Токсины гриба поражают растения, отравляют семена зерновых.

Наверняка вам не раз встречался в продаже вот такой лук или другой овощ, пораженный черной плесенью: ни в коем случае не приносите его домой
Не только споры грибка, но и его фрагменты могут находиться как вне помещений, так и внутри жилища, концентрируясь в домашней пыли. Риск возникновения колоний Alternaria tenuis выше в домах с влажной атмосферой.
В эта плесень распространяется быстрее, чем в бетонных домах. Распространение её спор происходит в ветреные солнечные дни при невысокой влажности воздуха.
Помимо прямого инфицирования, которое случается при непосредственном контакте человека с Alternaria tenuis, может произойти отравление токсинами этой плесени.
Токсины могут спровоцировать приступ бронхиальной астмы, возникновение дерматита. Кроме того, эта плесень опасна и проявлением аллергических реакций у людей, которые чувствительны именно к Альтернария альтерната.
Что способствует распространению грибка?
Итак, мы выяснили, чем именно опасна плесень для организма человека. Очевидно, что необходимо принимать все возможные меры, чтобы в доме её не было.
Следует знать, какими именно путями эта зараза проникает в жилище, чтобы, проводя профилактические мероприятия, не допускать её появления.
Тепло и влажно – вот два важнейших условия для развития плесневых грибков. Оптимальные параметры для их существования – 70% влажность и температура от +18 до +25 градусов.
Если же помещение ещё и не вентилируется, то все возможности для образования плесневых колоний налицо.

Гораздо проще предотвратить появление плесени, чем бороться с последствиями её воздействия на организм, когда всё уже произошло: не упускайте время
Понятно, что для устранения этих факторов никакие значительные материальные затраты не потребуются. Проветрить помещение не так уж и сложно.
Но, кроме названных выше, есть и другие причины возникновения и развития плесени. Люди о них, как правило, и не подозревают. Появление плесени может оказаться побочным эффектом развития строительной отрасли и появления инновационных строительных технологий.
Причина #1 — двери и окна из пластика
Те, кто установил в своём доме хотя бы одно пластиковое окно, уже успели оценить те преимущества, которые оно обеспечивает. Такие окна обладают замечательными звукоизолирующими свойствами.
Они способствуют сохранению тепла. За ними легко и просто ухаживать. Кроме того, изделия из пластика долговечны и ремонтопригодны. Но если их неправильно эксплуатировать, они могут стать причиной появления плесени.

Проблема с образованием конденсата на стеклах пластиковых окон особенно актуальна в кухне, где могут готовиться блюда на бульонах, компоты и так далее
Пластиковые окна и двери закрываются практически герметично. То есть та циркуляция воздушных масс, которая возникала в период существования рам из «дышащей» древесины, теперь нарушена.
Если же количество стекол в стеклопакете подобрано неправильно, само изделие не соответствует стандартам качества, а монтаж выполнен с нарушениями существующих норм, то на поверхности стекол может образоваться конденсат.
Получается, что изделия из пластика создают идеальные условия для повышения влажности в жилище. Осознав эту опасность, производители окон постарались предусмотреть все возможности для быстрого проветривания помещения. Одно из таких решений – .
Именно регулярное проветривание комнат, невзирая на погодные условия и на время года, помогает избежать образования плесневых колоний в доме.
Причина #2 — любимый всеми гипсокартон
И как же не любить этот строительный материал, если с его помощью так легко и быстро можно выровнять любую горизонтальную или вертикальную поверхность. Именно гипсокартон позволяет в кратчайшие сроки возводить перегородки любой конфигурации.
Этот совсем недорогой материал действительно удобно использовать и в ремонте, и строительстве, поэтому он пользуется заслуженной популярностью.

Конечно, конструкции из гипсокартона – это удобно, красиво и экономно, но, создавая их не забывайте, что этот материал гигроскопичен
Но и у этого материала есть существенный изъян: гипсокартон отлично впитывает влагу, позволяя ей надолго задерживаться внутри.
Чтобы при использовании гипсокартона не оказаться в плену у черной плесени, необходимо строго соблюдать технологию монтажа, помнить о том, что у смесей должно быть время для высыхания.
В комнате с гипсокартоном нужно создавать противогрибковый микроклимат.
В помещениях с повышенным уровнем влажности следует использовать специальный гипсокартон, рассчитанный на подобные условия эксплуатации. Кроме того, в растворы, применяемые в процессе работы, должны добавляться противогрибковые препараты.
Причина #3 — некачественная вентиляция
Окно в ванной комнате – настоящая редкость. Как правило, планировка наших квартир не предполагает не только окон в санузлах, но и достаточно эффективной вентиляции.
Между тем, в ванных может образовываться много влажного воздуха в результате сушки белья или водных процедур, для которых это помещение и предназначено. Естественным вытяжным каналам трудно с ним справится.

Плохая вентиляция в ванной в сочетании с повышенной влажностью этого помещения и теплом, создают идеальные условия для образования и распространения черной плесени
Одним из методов решения этой проблемы является использование . Благодаря этой мере проблема избыточной влажности будет решена, а заодно не будут возникать и условия для развития плесневой микрофлоры.
Подробнее о выведении плесени в ванной .
Причина #4 — сырые подвалы и влажные стены
Довольно часто просчеты в проектировании могут приводить к тому, что во время дождя стены или угловые части построек намокают, а в холодную часть года промерзают.
Такая же проблема возникает при отсутствии водосточных труб или при их засорении. Если на это не обращать внимания, то со временем на стенах могут образовываться колонии плесени.
Постепенно грибок прорастает сквозь кирпичную кладку или панели и оказывается уже внутри помещения. Вторжение произойдет ещё быстрее, чем это можно предположить, если в кирпичной кладке имеются трещины, или стыки панелей недостаточно хорошо гидроизолированы.

Обидно, если вы принесете в дом черную плесень, ещё и заплатив за продукт, на котором она находится, деньги: из зараженного зерна получается зараженный хлеб
Источник плесени может находиться в сыром подвале. В нем колонии могут образоваться и размножиться, а затем, используя вентиляционные ходы, они распространятся по всем помещениям.
В частном доме это проблему решают самостоятельно обустройством качественной . Чтобы устранить сырость в многоквартирном доме придется обращаться в ЖЕК.
Неисправные канализация и водопровод тоже создают условия для развития грибков.
Черную плесень мы можем занести в свой дом и сами, не желая того. Достаточно купить в магазине хлебопродукты, выпеченные из зараженного зерна.
Такой хлеб очень быстро покроется налетом, а затем и плесенью. Есть его ни в коем случае нельзя: это опасно для здоровья. На корм животным он тоже не годится.
Его следует упаковать в полиэтиленовый пакет, а затем отправить в мусорный бак вне помещения.
Тонкости борьбы с черной плесенью
Если вы обнаружили черную плесень у себя в квартире, то с таким соседством необходимо расправиться, не мешкая. Чем дольше колонии будут располагаться в вашем жилье, тем больше вреда здоровью они могут нанести, и тем сложнее их будет выжить.
Галерея изображений
Фото из
Готовые средства для борьбы с плесенью
Уксус с содой и лимонной кислотой
Использование перекиси водорода
Высушивание влажных поверхностей
Необходимо сразу оговориться, что применение бактерицидных средств в борьбе с плесенью не поможет. Эти препараты созданы для уничтожения бактерий, а не грибков.
Вам предстоит битва с плесневыми паразитами, для которой нужны специальные .

Ультрафиолетовое излучение, испускаемое лампой, губительно для колоний грибков, не зря вне строений черная плесень предпочитает тенистые местечки
Отличным и весьма действенным способом избавления от плесени является обработка помещения с помощью УФ-лампы. Под влиянием ультрафиолетовых лучей споры погибают.
При использовании этой лампы необходимо соблюдать некоторые меры безопасности: удалить из обрабатываемой комнаты домашних любимцев, включая птиц и аквариумных рыбок, а также вынести из помещения все живые цветы.
Существуют и иные методы борьбы с плесневыми грибами:
- Если колонии плесени расположились на конкретных предметах, которые можно вынести вон, их обязательно нужно удалить за пределы жилья. Отправьте на свалку старые обои, заплесневевший текстиль или зараженную шпатлевку.
- Во все строительные и отделочные смеси, которые используются при строительстве частного дома или при ремонте вашей квартиры, следует добавлять специальные противогрибковые препараты и антисептики. Часто плесень приживается в межплиточных швах на кухне и в санузле. Значит, затирке следует уделить особое внимание.
- Пораженные грибами участки можно обработать и специальными промышленными препаратами. В случае их отсутствия используют средства, которые есть у каждой хозяйки.
Если пятна плесени появились на непористых поверхностях, к которым относятся, например, кафель или зеркало, то для их ликвидации можно воспользоваться такими популярными веществами: отбеливатель «Белизна», нашатырь, раствор буры или уксус.
Можно нанести на пораженную поверхность перекись водорода, а, спустя 15 минут, промыть участок водой. Отлично зарекомендовала себя и пищевая сода.

Все поверхности, на которых присутствуют следы плесени, должны быть безжалостно удалены: лучше сделать эту работу на совесть один раз, чем бесконечно возвращаться к ней
Сложнее дело обстоит при появлении колоний на штукатурке: всю пораженную часть необходимо механически удалить. Лучше делать это металлической щеткой.
Зачистка проводится на всю глубину проникновения плесени. Межплиточные швы тоже прочищают острым инструментом.
Желательно просушить очищенную поверхность с помощью промышленного фена и обработать антисептиком. Причем обрабатывать следует не только тот участок, с которого удалена плесень, но и примыкающие поверхности.
Какой бы из способов, перечисленных выше, вы не выбрали, важно, чтобы плесень была уничтожена или, на худой конец, удалена за пределы квартиры. Игнорировать её появление нельзя. Это слишком опасное соседство, от которого любыми путями нужно избавляться.

Мы не предлагаем вам использовать в качестве средства индивидуальной защиты противогаз или спецодежду, но очки, респиратор и резиновые перчатки быть должны
Необходимые меры безопасности
Учитывая то, что споры, частицы самой плесени и токсины, которые она выделяет, могут распространяться с воздушными потоками, собираясь на борьбу с колониями грибков, необходимо обезопасить свои дыхательные пути и кожу от нежелательных контактов.
Техника безопасности:
- Не пренебрегайте такими средствами индивидуальной защиты как респиратор, непромокаемые перчатки и защитные очки.
- Чтобы споры, которые были удалены с одной поверхности, не прижились на другой, поверхности мебели и пола необходимо накрыть клеёнкой, которую не жаль потом выбросить, или полиэтиленовой пленкой.
- Все, что можно вынести из помещения на время уборки, лучше их него удалить. В ванной комнате это могут быть, например, мочалки, щетки, полотенца и шторы.
- Если ситуация серьёзная и плесень умудрилась захватить большие площади помещения, все предметы, на которые могут попасть споры грибков, следует укутать пленкой. Выбирайте пленку потолще, чтобы защита была надежной. На своём здоровье экономить нецелесообразно: потом больше израсходуется на лекарства.
- Ни в коем случае во время уборки не включайте вентилятор. Споры плесени легко распространяться по всему помещению, а потом от них просто не будет спасения: проявляться они могут неожиданно и в самых неподходящих местах.
- Не используйте для удаления колоний грибков бытовой пылесос. На внутреннюю поверхность этого бытового прибора могут попасть сами споры или токсины. Споры в пылесосе не погибают, а просто ждут своего часа и подходящих условий для возрождения колоний.
- А вот осушитель, если в доме есть такой прибор, следует включить. Подсушенный воздух лишит микроорганизмы шанса на продолжение существования.
- После уборки зараженного помещения, необходимо все тряпки, щетки, перчатки и пленки выбросить вместе с респиратором.
Борьба с плесенью – неизбежное мероприятие на тот случай, если плесень уже завелась. Но гораздо лучше не допускать её возникновения, не создавая условий для развития колоний грибков.
Галерея изображений
Фото из
Использование антисептиков в отделке
Регулярная уборка с просушиванием помещений
Обработка профилактическими противогрибковыми средствами
Вентиляция как мера предотвращения
Выводы и полезное видео по теме
О том, что плесень опасна, можно много писать, но это не произведёт такого впечатления, как рассказы тех, кто однажды подвергся её воздействию.
Хорошо, что когда люди вовремя осознают, с чем связаны их неприятности и плохое самочувствие. Следующий видеоролик поможет разобраться с проблемами, которые возникают от воздействия черной плесени:
Наглядно демонстрирует приемы профилактики и борьбы с колониями грибка вот это видео.
Победить своего бархатистого врага совсем не просто, но возможно. Гораздо важнее обеспечить такие условия жизни в вашем доме, чтобы плесень в нем вообще не заводилась. Не оставляйте ей ни единого шанса на жизнь.
Возможно у вас тоже есть опыт борьбы с коварной плесенью? Пожалуйста, расскажите о проверенных методах ее уничтожения. Комментируйте материал и оставляйте вопросы по теме.
sovet-ingenera.com
как избавиться в домашних условиях от вредного грибка?
Многие не знают, как избавиться от плесени в квартире, пока проблема не коснется их лично. Высокая влажность при плохой вентиляции приводит к появлению плесени. Невидимые глазу споры резво разносятся по помещению в поисках укромных уголков, и вскоре жилье наполняется неприятным запахом, а на поверхностях появляется мерзких темный налет.

Главное условие уничтожения плесени
Грибок на стенах может пережить многое. В некоторых квартирах при регулярно проводимых процедурах он годами терроризирует жильцов. И дело не в неправильном выборе средств или проведении процедур чистки – в этом деле поможет даже обычный фурацилин. Споры прячутся в далекие щели, а потом радостно вылезают наружу, где их не отмыть. Чаще всего приходится интересоваться, как избавиться от черной плесени, реже встречаются другие разновидности.
Почему? Проблема в микроклимате жилья. До тех пор, пока влажность не становится стабильно низкой, положительный эффект работ может быть только временный.
Необходимо провести ряд манипуляций:
- проверить систему вентиляции и теплоизоляции;
- отдельно проверять влажность на кухне и ванной комнате, устранять неполадки сантехники;
- установить систему электрического обезвоживателя;
- если есть места, где краска пошла буграми, снять ее, обработать поверхность антисептиком, чтобы вывести плесень, и закрасить свежим слоем;
- моющими средствами на уксусной основе уничтожить споры в трещинах и щелях;
- не сушить в квартире вещи, расправлять шторы для душа, приобрести сушку для полотенец в ванную комнату.
Если все делать правильно, то после выполнения этих элементарных правил средства от плесени на стенах принесут ожидаемый эффект, и вы распрощаетесь с вредным гостем.

Направления борьбы
- Первым делом грибок на стенах должен чиститься механически. Та же процедура проводится с половым покрытием, потолком и мебелью, которая тоже оказалась поражена. Чаще всего это часть со стороны влажной стены или в углах.
- Вопрос о том, как избавиться от плесени в доме, давно беспокоит строительные компании. В их лабораториях произведены химические средства, которыми необходимо обработать не только пораженные поверхности, но и близлежащие. Однако начинать бороться стоит все-таки с более мягких, народных, антисептиков. Если случай не запущенный, их будет вполне достаточно.
- Не жалея, выбросить вещи, которые оказались поражены плесенью.
- Тщательно проветрить помещение от запаха грибка и химии.
- Контролировать влажность в помещении, вовремя устранять ее источники. Это особенно сложно выполнить в частном доме.

Фурацилин может существенно облегчить борьбу с пятнами плесени
Универсальные народные средства
Можно попытаться избавиться от плесени в комнате доступными и сравнительно безобидными народными антисептиками. Даже знакомые с детства фурацилин и перекись станут надежными помощниками. Готовить из них противогрибковые растворы легко, средств нужно потратить минимум, а делать чистку можно в специально выделенном халате и резиновых перчатках.
Вот несколько рецептов, которые можно использовать на разных видах поверхности без вреда, чтобы вывести плесень.
4 ст. л. буры, полстакана белого уксуса и 4 стакана подогретой воды смешать до однородной консистенции и из пульверизатора обработать раствором поверхности квартиры. Через 10 минут все тщательно оттереть досуха и повторить процедуру удаления грибка с антисептиком снова.
На те же 4 стакана воды – полстакана отбеливателя. Все тщательно смешивается и наносится на окрашенные стены и другие гладкие поверхности, например плитку или вагонку. Протереть, нанести еще раз на 5-10 минут и снова протереть.
Протереть уксусом поверхности несколько раз с интервалом в 1 час.
Перекись водорода в 3%-м варианте отлично действует на грибок и продается в любой аптеке.
Совет
Антисептик имеет отбеливающие свойства, стоит это учитывать при применении.
В отличие от предыдущих противогрибковых народных рецептов, этот раствор советуют не пытаться полностью отмыть с поверхности. И это полностью безопасно, поскольку в него входит только вода (1 стакан) и сода (1 ч. л.). Оставаясь на стенах, сода длительное время может бороться с плесенью.
Раствор фурацилина, если его делать самостоятельно, поможет против грибка не хуже. Необходимо 10 таблеток аптечного фурацелина растереть и растворить в стакане теплой воды. После этого тщательно протереть жидкостью пораженные поверхности.
Совет
Народные средства не гарантируют удаление плесени, однако вероятность положительного результата велика. Лучше потратить лишнее время, работая с такими безобидными веществами, как сода или фурацилин, чем дышать агрессивными химическими препаратами.

Особенности работ в зависимости от видов поверхности
Перед тем как избавиться от грибка на стенах, окрашенных краской, надо убрать слой в местах, где покраска пошла трещинами и буграми. В противном случае споры, которые там однозначно притаились, скоро опять покажутся на поверхности.
Намного хуже дело с гипсокартонными и навесными потолками. Их проблематично обработать, поскольку поверхности пористые, а грибок на стенах и потолках проникает внутрь глубоко. Если универсальные рецепты не дают результата, а обращаться к специалистам нет возможности или желания, придется пораженную часть банально заменить.
Обои любого качества часто обрастают грибком из-за неправильно проведенных ремонтных работ. Отмыть не получится, обои придется полностью убрать и обрабатывать под ними пористую стену.
Пористая стена требует особого внимания, так как она лакомый кусочек для грибков. Борьба с грибком на стенах начинается от очистки шпателем поверхности от грибка и рыхлой штукатурки, куда могли попасть споры. Далее наждачной бумагой зачищается вся поверхность, включая ранее очищенные участки, и начинается обработка раствором фурацилина. Это надо делать неоднократно, 5-6 раз. И только после этого в ход идет антисептик и штукатурка.

Работа со специальными средствами
Поскольку плесень устойчива ко многим антисептикам, разработки фунгицида у химиков довольно беспощадны и для человеческого организма. Работать с ними необходимо, тщательно соблюдая все правила техники безопасности, включающие и строительный респиратор.
От материала поверхности зависит, чем обработать стены от плесени. Мало того, и разновидности грибка обрабатываются разными химикатами. Так что перед тем, как убрать налет фунгицидом, внимательно изучите рекомендации к его использованию и свои стены. Определившись, с чем приходится бороться, можно провести чистку намного эффективнее и за меньшее время.
Чем обработать стены от плесени и как удалить грибок, чтобы он не возвратился снова, хорошо знают специалисты. Конечно, в домашних условиях можно самостоятельно решить эту проблему, но обращение к профессионалам избавит от больших трат времени и физических сил, сбережет ваше здоровье. Споры, летающие в воздухе, токсичны, да и пыль ремонта не добавит вам здоровья. Профессионалы могут убрать плесень, используя средства защиты, выполняя все этапы работ правильно и в быстром темпе.
mschistota.ru
Как избавиться от плесени в квартире | Здоровая жизнь | Здоровье
В режиме нон-стоп
Достала плесень? Она портит не только интерьер. И появиться может где угодно: на кафеле ванной, на кухне и даже в комнатах. По сути плесень – это колонии грибков, которые выделяют токсичные микоспоры, причем в большом количестве. Они оседают в легких, на коже, проникают в организм через ее поры, попадают в пищу и могут «довести» до воспаления верхних дыхательных путей, бронхиальной астмы, хронического насморка, дерматоза, конъюнктивита и т. д.
Еще хуже, если мельчайшие токсичные частицы «проберутся» в кровеносную систему: со временем это может вызвать поражения печени и почек, желудочно-кишечного тракта, стать причиной частых головных болей, непонятных «приступов» усталости.В чем причины?
Появление плесени в доме – сигнал о том, что прежде всего нужно бороться с повышенной влажностью. Но, чтобы эта война окончилась вашей победой, нужно знать причины образования зловредных грибков. А они могут быть самыми разными. Неприятная история, когда плесень вырастает на откосах пластиковых окон, но и здесь побороть ее вполне реально.Самый плохой вариант – «грибковые наросты» на стенах. Такое случается, когда нарушена их гидроизоляция, появляются микротрещины в межпанельных швах, в самих плитах, в их внутренних полостях.
Локальная оборона
Победить плесень на стенах ванной или кухни не так уж и сложно. Проверьте систему домовой вентиляции: поднесите к вентиляционной решетке зажженную спичку. Тут же погасла? Промойте отверстие и повторите тест: может шахта забилась паутиной или мусором. Результат тот же самый? Возможно, шахту перекрыли соседи, делая ремонт, – вызывайте работника ЖЭКа (или обслуживающей дом компании), чтобы проверить систему домовой вентиляции.
Теперь можно браться за уничтожение бархатного врага. В магазинах сегодня немало средств для борьбы с плесенью. Если грибков на стенах немного, помогут такие проверенные средства, как 9%-ный уксус или раствор медного купороса. Обрабатывая поверхности, не забудьте о резиновых перчатках, маске и защитных очках. Затем плесень нужно соскрести со стен и как следует вымыть их щеткой.
Если воздух плохо циркулирует в квартире из-за пластиковых окон, чаще проветривайте помещение. В доме маленький ребенок, боитесь, что он простудится? Можно установить на раме специальное приточное устройство, которое будет обеспечивать безопасную дополнительную вентиляцию.Двойной удар
Самый трудный случай – мокнущая стена. Гидроизоляция изнутри, утепление с использованием самых современных строительных материалов – лишь временное решение проблемы. Кардинальное – ремонт стены снаружи. Обратитесь с заявлением в организацию, отвечающую за эксплуатацию дома (ДЭЗ, частная управляющая компания, ТСЖ и т. д.). Ее представитель должен, осмотрев помещение, составить акт и организовать работы по герметизации.
Время идет, а дело ни с места? Обращайтесь в территориальные отделения жилинспекции, Роспотребнадзора. Отправляйте заявления заказным письмом, сохраняя у себя вторые экземпляры, а также полученные ответы. Не исключено, что придется обращаться в суд. В общем, вариант это долгий и нервный.
Но есть и второй – обратиться к промышленным альпинистам: они выполнят работы по заделке швов и трещин снаружи стены.
Кто бы ни занялся наружным ремонтом, не обойтись и без внутреннего: с зараженных поверхностей необходимо удалить обои, шпаклевку, штукатурку. Затем обработать стену противогрибковым составом, тщательно ее высушить и провести ремонт.
Личное мнение
Георгий Ланской, журналист, писатель:
– К счастью, уже лет 12 эта проблема мне не знакома, так как в моей квартире очень сухо. А вообще, убирать в квартире надо чаще, и тогда никакой плесени у вас не будет.
Смотрите также:
aif.ru
Как избавиться от плесени в квартире своими руками
Плесень – это явление достаточно распространенное. Постоянно разрастающиеся пятна не только неэстетично выглядят. Плесень приносит намного больше проблем: неприятных запах и вред здоровью. В этой статье мы опишем основные способы, как избавиться от плесени в квартире на стенах, потолке, обоях.
Домашний враг
 Может быть причиной различных болезней
Может быть причиной различных болезней
Среди самых распространенных недугов, которые могут проявиться у каждого человека, живущего в квартире с плесенью, выделяют:
- подавление иммунной системы;
- аллергические реакции;
- астма;
- хронический кашель и насморк.
Заниматься их лечением бессмысленно, так как необходимо устранить первопричины – плесень. Избавившись от плесени навсегда, можно распрощаться и с болезнями. Для решения этой проблемы необходимо, прежде всего, найти причину ее появления и размножения. Чаще всего причины ее образования заключаются в элементарных вещах: постоянная повышенная влажность воздуха и слабая вентиляционная система.
 Плесень вокруг оконного проема
Плесень вокруг оконного проема
Несмотря на то, что на сегодняшний день в строительстве используются инновационные материалы, это не всегда спасает от поражения грибком. Чаще всего плесень можно обнаружить:
- в туалете;
- в ванной;
- на кухне;
- в холодильнике;
- вокруг оконного проема.
Первым признаком ее проявления станет специфический запах: острый и сырой. Следом за возникшим неприятным запахом появляются и темные пятна.
Если не решить проблему с нормализацией влажности в помещении и обустройством правильной системы вентиляции, то плесень будет появляться с определенной периодичностью.
Основные методы борьбы
 Чистка с использованием моющих средств
Чистка с использованием моющих средств
Если вы приобрели квартиру с «проблемами», то прежде, чем въехать в нее, необходимо узнать, как вывести плесень и принять все меры по ее устранению. В частности, основным средством является генеральная уборка:
- мытье;
- чистка;
- использование моющих средств;
- применение чистящих средств с агрессивными веществами.
Если этого комплекса недостаточно, то очистить придется весь дом. Вспомогательным веществом, которое поможет удалить грибок на стене, является обычная пищевая сода. Жесткую металлическую щетку необходимо обмакнуть в соду и обработать ею зараженную поверхность. Этот вариант считается одним из самых действенных и одновременно безопасным, поэтому его можно применять при очищении детских комнат, а также мягкой мебели. В последнем случае необходимо заменить металлическую щетку на губку из поролона.
 Очистка содой
Очистка содой
Можно не удалять остатки соды с поверхностей, так как мелкие частицы будут препятствовать образованию новых загрязнений.
Еще одним универсальным домашним средством можно назвать уксус. Им следует проводить очищение и обеззараживание поверхностей на кухне. Для этого следует развести его в воде и, смочив мягкую тряпку, протереть:
- холодильник;
- полки;
- шкафы;
- подоконники и откосы окна;
- мебель;
- хлебницу.
Чтобы избавиться от неприятного и резкого запаха уксуса, достаточно добавить в раствор несколько капель любого эфирного масла.
 Эфирное масло чайного дерева
Эфирное масло чайного дерева
Если же речь идет об устранении плесени на стеклах, кафеле или сантехнике, то лучше отдать предпочтение нашатырному спирту. Соблюдайте особую осторожность, работая с нашатырем в закрытом помещении, так как при неправильной пропорции можно надышаться вредными парами. Более сильнодействующим средством является отбеливатель (белизна), в состав которого входит хлор. С его помощью можно провести очищение только неокрашенных поверхностей в доме, так как высоко агрессивные частицы могут удалить и цветное покрытие.
 Белизна
Белизна
Стоит заметить, что не со всех поверхностей можно удалить отложения. Есть и такие, которые плесень безвозвратно повреждает. В этом случае их будет проще выкинуть или сжечь. Так, если плесень обнаружена на обоях, книгах, деревянных изделиях и мягкой мебели с неплотной обивкой, то лучше убрать их из квартиры.
Очистительные работы по устранению грибка необходимо проводить в резиновых перчатках и респираторе, так как при попадании спор на кожу или в органы дыхания может развиться отравление.
Подручные средства

Чтобы избавиться от черной плесени, которая наиболее распространена, можно воспользоваться простыми средствами, которые есть у каждой хозяйки:
- Эфирное масло чайного дерева. Все знают о его успокаивающем эффекте при раздражениях и укусах, но не каждый человек догадывается и о других возможностях его применения. Наличие резкого запаха не должно смущать, так как он достаточно быстро исчезает. Чтобы быстрее избавиться от запаха – организуйте проветривание. Важно отметить наличие прекрасных антибактериальных и антигрибковых свойств, которых будет вполне достаточно для борьбы со всеми видами плесени. Использовать его очень просто: в контейнере пульверизатора разводят воду и масло чайного дерева в пропорции 1:1, им и обрызгивают зараженную поверхность.
- Грейпфрут. Экзотическое средство от плесени и грибка. Главным преимуществом использования фруктов или же эфирного масла является отсутствие запаха. Купить его можно в аптеке или же специализированном Интернет-магазине. На 2 стакана охлажденной воды понадобится в среднем 20 капель экстракта. Наносить на поверхности можно с помощью распылителя.
Есть еще несколько средств, которыми можно убрать образования плесени. Но, стоит заметить, что некоторые из них токсичны, поэтому применять их необходимо только в крайнем случае и с особой осторожностью.
- Бура. Этот вариант при использовании не выделяет токсических газов. Но провести очищение текстиля не получится, потому как он подходит исключительно для твердых поверхностей. Так, бура поможет справиться с загрязнениями на потолке или стенах.
- Аммиак. Рекомендуемая пропорция воды и аммиака – 1:1. Смешивать его с отбеливателем строго запрещено, так как в результате полученная смесь будет выделять большое количество токсичных паров, вредных для организма человека. После нанесения на грибковые образования необходимо оставить поверхность на пару часов, а затем тщательно промыть чистой водой.
- Перекись водорода. Влить 3%-ную (аптечную) жидкость нужно в пульверизатор, а затем разбрызгать его на окнах или на зеркалах. По истечении 10 минут смыть.
После любого вида очищения поверхности промывают чистой водой и протирают насухо.
Магазинные средства
 Спецсредства из магазина
Спецсредства из магазина
Вышерассмотренных способов очищения вполне достаточно, чтобы решить проблему. Но не всегда можно спастись народными средствами. В этом случае стоит отправиться в хозяйственный магазин и рассмотреть соответствующий ассортимент там. Среди самых популярных марок можно выделить:
- Део-антиплесень;
- Баги Анти-Плесень;
- NEOMID;
- Mogel-Fri;
- Сагротан;
- Мёгель-фри и другие.
Все они представлены в форме жидких растворов и продаются в обычных пластиковых контейнерах с установленным распылителем. Это позволяет использовать его в любое время без нанесения вреда окружающей среде. Но, все же, стоит помнить о правилах безопасности и четко соблюдать технологию применения. Чтобы решить какое из них подействует в вашем случае более эффективно, необходимо изучить состав, инструкцию по применению, а также общую информацию, которую приводит для ознакомления производитель.
К более дорогостоящим средствам можно отнести паровые очистители, которые быстро справляются с живыми организмами в самые короткие сроки. Из-за высокой цены такой способ подойдет для предприятия или организации.
Бережем свое жилье
 Необходимо проветривать
Необходимо проветривать
После того как вы провели полное очищение квартиры своими руками, необходимо принять все меры предосторожности, чтобы плесень снова не появилась. Чтобы добиться желаемого, достаточно решить всего несколько вопросов:
- Организация качественной и сильной вентиляции всех комнат. Проверить мощность тяги можно при помощи простой зажженной спички или свечи. Если пламя не изменяет направление, то тяга отсутствует.
- Высокая герметичность пластиковых окон. Этот показатель очень хорош в случае рассмотрения потерь тепла, но для хорошей циркуляции воздуха следует установить специальные вентиляционные клапаны. Они обеспечат поступление свежего воздуха в необходимом количестве.
- Ежедневные проветривания. Если каждый день будут открываться или приоткрываться окна и форточки, то под обоями не будет расти грибок. Вполне достаточно будет 10–15 мин в день.
- Источники повышенной влажности воздуха. К таковым стоит отнести плохую изоляцию промежутков между панелями, сырость строительных материалов, вода на поверхностях, большое количество цветов и многое другое. В этом случае необходимо устранить все проблемы, чтобы решить проблему максимально эффективно.
Рекомендуется для профилактики повторного появления грибка проводить обработку поверхностей специальными препаратами – биоцидами. Они уничтожают различные микроорганизмы и споры.
Проводить очищение квартиры от плесени самостоятельно можно, но только в том случае, если зараженная поверхность не превышает половины квадратного метра. В запущенных случаях рекомендуется воспользоваться услугами специалистов, которые работают в соответствующих организациях и инстанциях.
Выводим запах плесени

Выполнив вышеизложенные рекомендации можно приступать к борьбе с неприятными запахами. Например, можно использовать ароматические свечи. Кроме того, необходимо предпринять и другие меры:
- Для дезинфекции помещения при уборке добавляйте в воду масло чайного дерева.
- Для качественной борьбы с неприятным запахом плесени можно установить ионизатор воздуха.
Какая бы там ни было постарайтесь удалить источник запаха.
Из одежды и стиральной машины

Влага в квартире или некачественная сушка одежды могут привести к тому, что на одежде, хранящейся в шкафу, разовьется плесень. Она будет распространяться на все предметы гардероба, откуда и появляется затхлый запах. С течением времени плесень повредит ткани одежды и многие предметы гардероба вам попросту придется выбросить. Как уже упоминалось причиной образования плесени на одежде может стать ее некачественная сушка. Кроме того, плесень может образоваться в стиральной машине и шкафу.
Если у вас есть вещи, пропитанные запахом плесени, то их прежде всего нужно просушить на солнце. Потом застирайте их в стиральном порошке, предназначенном для выведения запахов. Затем снова высушите одежду на солнце. Чтобы вещи не отсырели в шкафу снова, проложите их листами для сушки. Они впитывают в себя влагу, таким образом, предотвращая образование плесени. Чтобы эффект от таких листов был ожидаемым, вам нужно своевременно осуществлять их замену.
 Как быть с одеждой
Как быть с одеждой
Если выяснилось, что причиной запаха плесени является стиральная машина, то самое простое, что вы можете сделать – это не закрывать крышку машинки после стирки. Если это не помогло, то в барабан нужно залить чашку белого уксуса или отбеливателя (можно даже использовать для промывки небольшое количество моющего средства), а затем прополоскать его теплой водой.
Если запахом плесени пропиталось полотенце, то прополощите его в горячей воде с добавлением стакана белого уксуса. После этих действий постирайте его в машине с порошком при большой температуре. Сушить полотенце нужно на солнце по возможности.
Если источник распространения плесени – это шкаф, то нужно его очистить. Стирка одежды не даст никакого результата.
Из шкафа

Если плесень образовалась в шкафу, то нужно убрать из него всю одежду, выстирать ее по методике, описанной выше, а сам шкаф очистить. Чтобы результаты чистки шкафа были максимальными следует определить причину роста плесени. Например, это может быть конденсат от батареи, которая спрятана за шкафом, высокая влажность воздуха в помещении или влажная ткань на полу шкафа. Если вы устраните подлинную причину появления плесени, то после уборки шкафа и стирки одежды, дублета быть не должно.
После очистки шкафа, оставьте дверцы от него открытыми, чтобы полочки и стенки полностью просохли. Установите в комнате со шкафом осушитель или вентилятор. Так, вы сократите уровень влажности в помещении.
 Ароматические специи против запаха плесени
Ароматические специи против запаха плесени
После этого нужно обработать полочки и стенки шкафа специальным раствором. Приготовьте его из уксуса и теплой воды с расчета 1:1. Также можно сделать дезинфицирующий раствор из теплой воды и нескольких капель отбеливателя или какого-либо чистящего средства.
Ни в коем случае не смешивайте отбеливатель/белизну с другими чистящими средствами!
После дезинфекции шкафа, протрите его внутренние стенки тряпкой, промытой в холодной воде. Оставьте шкаф открытым на 2–3 дня, но не складывайте в него пока одежду. Убедитесь, что в нем не осталось сырости и влаги. Если после всех мероприятий плесень и неприятный запах от нее ушел, то можно дальше пользоваться шкафом в обычном режиме. Если не все так радужно, то проведите его очистку снова или постарайтесь выявить причину образования плесени. Может быть, нужно будет уменьшить влажность воздуха в помещении.
Видео
Дополнительные рекомендации вы можете получить, посмотрев видеоролик:
kakpravilnosdelat.ru
Как бороться с плесенью и грибком на стенах квартиры, средства удаления
 Борьба с плесенью и грибком на стенах в квартире. Эффективные средства удаления.
Борьба с плесенью и грибком на стенах в квартире. Эффективные средства удаления.На штукатурке и обоях появились черные пятна, от стен несет, как от школьной половой тряпки, а смотреть в ту сторону просто противно. Что же, пришло время объявлять войну; засучивать рукава и двигать мебель. Борьба с грибком и плесенью в квартире не минутное дело и редко происходит без нарушения привычного порядка вещей.
Как избавиться от грибка и плесени на стенах — причины появления
Для начала следует определиться с возможными причинами возникновения грибка. Ибо, зная источник проблемы, можно впоследствии не допустить возникновение плесени. Первая вероятная причина появления грибка — это избыточная влажность. Особенно это важно в холодный период времени, когда на окнах собирается конденсат. Влага, скапливаясь на подоконнике, заполняет щели и стыки, а испаряясь — попадет на откосы и края стен. Помимо этого, появлению грибка может способствовать неравномерное отопление, плохая вентиляция и даже излишнее количество домашних растений или аквариум. Таким образом, необходимо в первую очередь обеспечить комплекс мероприятий для устранения вышеперечисленных недостатков, а уж потом бороться с плесенью и грибком на стенах и потолках квартиры или дома. И первое, что нужно сделать — обеспечить беспрепятственную циркуляцию воздуха в местах, где появилась плесень: для начала отодвинуть мебель от стен и регулярно проветривать помещение. Желательно открывать окна несколько раз в день минут на пять. Особенно это важно после ручной стирки или длительного приготовления пищи. В зимне-осенний период нужно следить за тем, чтобы тепло от радиаторов отопления беспрепятственно поступало к окнам. Возможно, для этого придется сделать небольшие решетки в подоконниках. Если же плесень появилась на кухне или в ванной комнате, то в первую очередь следует проверить функционирование домовых вытяжек и не оставлять надолго закрытой дверь ванной комнаты. Что касается электрических вытяжек, то при наличии такой вытяжки, настоятельно рекомендуется организовать дополнительную вентиляцию.
Начинаем бороться с плесенью в квартире
Борьба с грибком на стенах дело сложное, тяжелое и не всегда оканчивается безоговорочной капитуляцией. Впрочем, не все так плохо. Нужно только скрупулезно выяснить возможные причины появления грибковой плесени и наметить дальнейший план действий. Для начала необходимо определиться с размерами «зоны поражения». Если это небольшой участок стены или оконного откоса, то можно ограничиться обработкой перекисью водорода или укусом. В качестве дешевого способа борьбы может применяться всем известная «Белизна» или «Domestos». Это самые простые народные средства от плесени на стенах. Кроме этого, популярностью пользуются водорастворимые составы и антисептики, с Уайт-спиритом или скипидаром в качестве разбавителя. Иногда производят удаление грибка со стен при помощи креозота или раствора медного купороса, но в последнее время эти способы считаются малоэффективными. Если же ничего не помогло, и грибок появился снова, значит, нужны более решительные действия. Тут уж простой обработкой не обойтись.
Борьба с грибком на стенах дело сложное, тяжелое и не всегда оканчивается безоговорочной капитуляцией. Впрочем, не все так плохо. Нужно только скрупулезно выяснить возможные причины появления грибковой плесени и наметить дальнейший план действий. Для начала необходимо определиться с размерами «зоны поражения». Если это небольшой участок стены или оконного откоса, то можно ограничиться обработкой перекисью водорода или укусом. В качестве дешевого способа борьбы может применяться всем известная «Белизна» или «Domestos». Это самые простые народные средства от плесени на стенах. Кроме этого, популярностью пользуются водорастворимые составы и антисептики, с Уайт-спиритом или скипидаром в качестве разбавителя. Иногда производят удаление грибка со стен при помощи креозота или раствора медного купороса, но в последнее время эти способы считаются малоэффективными. Если же ничего не помогло, и грибок появился снова, значит, нужны более решительные действия. Тут уж простой обработкой не обойтись.
Эффективное средство удаления плесени на стенах:
 Первым делом необходимо осуществить просушивание пораженного участка стены. При большом очаге поражения, возможно, понадобится просушить всю стену. Для этого необходимо удалить обои. После чего жесткой щеткой, или щеткой для чистки металла, убрать плесень во всех местах, где она появилась. Зачищать нужно тщательно, чтобы потом не повторять весь процесс заново. Если гипсовая штукатурка местами разрыхлилась или осыпается — там придется очищать стену до основания, пройдясь по всей пораженной зоне. Только после тщательного процесса очистки можно приступать к просушиванию стены. Для этого сгодится либо паяльная лампа (следует помнить о пожарной безопасности), либо строительный фен. Далее можно приступать к обработке стены антисептическим средством или иным специальным составом, который уничтожает грибки и бактерии, благо линейка выбора сейчас весьма широкая. Если стены чистились от штукатурки полностью, то можно провести более широкий комплекс работ по устранению грибка. Сначала необходимо нанести на стену средство для удаления плесени. Затем прогрунтовать грунтовкой глубокого проникновения с антисептическими свойствами. После чего подготовить гидроизоляционный состав (готовится из гидроизоляционной смеси) и валиком или кистью, нанести его на стену, обеспечив, таким образом, защиту от сырости. Затем необходимо снова прогрунтовать стену, используя грунтовку глубокого проникновения и уж затем приступать к оштукатуриванию. Как видно из вышеизложенного, борьба с грибковой плесенью — это, по своей сути, комплекс работ и мероприятий, реализация которых позволяет достаточно успешно справляться с этой неприятностью.
Первым делом необходимо осуществить просушивание пораженного участка стены. При большом очаге поражения, возможно, понадобится просушить всю стену. Для этого необходимо удалить обои. После чего жесткой щеткой, или щеткой для чистки металла, убрать плесень во всех местах, где она появилась. Зачищать нужно тщательно, чтобы потом не повторять весь процесс заново. Если гипсовая штукатурка местами разрыхлилась или осыпается — там придется очищать стену до основания, пройдясь по всей пораженной зоне. Только после тщательного процесса очистки можно приступать к просушиванию стены. Для этого сгодится либо паяльная лампа (следует помнить о пожарной безопасности), либо строительный фен. Далее можно приступать к обработке стены антисептическим средством или иным специальным составом, который уничтожает грибки и бактерии, благо линейка выбора сейчас весьма широкая. Если стены чистились от штукатурки полностью, то можно провести более широкий комплекс работ по устранению грибка. Сначала необходимо нанести на стену средство для удаления плесени. Затем прогрунтовать грунтовкой глубокого проникновения с антисептическими свойствами. После чего подготовить гидроизоляционный состав (готовится из гидроизоляционной смеси) и валиком или кистью, нанести его на стену, обеспечив, таким образом, защиту от сырости. Затем необходимо снова прогрунтовать стену, используя грунтовку глубокого проникновения и уж затем приступать к оштукатуриванию. Как видно из вышеизложенного, борьба с грибковой плесенью — это, по своей сути, комплекс работ и мероприятий, реализация которых позволяет достаточно успешно справляться с этой неприятностью.
Видео:
Видео:
Специально для строительного сайта http://sdelalremont.ru
sdelalremont.ru
Как избавиться от плесени на стенах в квартире: причины возникновения. Чем убрать плесень на стенах в квартире? – Автор Екатерина Данилова

На сегодняшний день не существует ни одного современного отдельного или строительного материала, на котором бы не заводилась плесень.
Везде присутствуют микроспоры, которые после попадания в благоприятную среду, тут же начнут размножаться.
Это чревато тем, что эти темные и зеленые точки способны спровоцировать огромное количество болезней, так как они являются очень сильными аллергенами.
Грибок способен распространяться по поверхности с большой скоростью, поэтому избавляться от плесени на стенах в квартире нужно как можно скорее.
Плесень на стенах в квартире: причины, как её определить
Прежде чем начать борьбы с такой неприятной проблемой, нужно узнать, что это вообще такое, почему она черного цвета и как с ней бороться.
Плесень – это группа микроорганизмов, таких как Strachybotrus Chartarun и Strachybotys Bcmpa, которые способны вызвать у человека большие проблемы со здоровьем. Она может появиться в каждом угле вашего жилища, в том числе на потолочных плитах, древесине (которая пропитана влагой), стенах, полу и коврах. Если у вас имеются проблемы с сантехникой и имеют место даже незначительные утечки, это можно привести к появлению и размножению плесени, поскольку лучше всего она себя чувствует именно во влажной среде. К примеру, если ваш ковер промок и не до конца просох, на нем может образоваться плесень, которая затем начнет распространяться по всей квартире.
Если дотронуться до плесневого пятна рукой в перчатке, можно почувствовать, что она очень слизкая. Чаще всего такая плесень бывает черного цвета, но иногда может иметь зеленоватые и желтые оттенки. Бывает так, что она появляется в «мертвых» для человеческого взгляда местах, и вы о ней даже не подозреваете. Но если вам вдруг стало тяжело дышать или появилась аллергическая реакция – внимательно осмотрите свою квартиру, возможно, это следствие возникновения плесени.
Плесень – это токсичный грибок, который способен с одинаковым успехом распространяться по деревянному, каменному и кирпичному покрытию. В случае с деревом этот грибок можно удалить только путем срезания зараженной части поверхности. Сделать это нужно как можно раньше, так как грибку будет достаточно одного года, чтобы полностью уничтожить древесину.
Откуда же она берется? Давайте определим основные причины возникновения плесени в помещении.
1. Промерзание наружной стены. Если штукатурка недостаточно надежно сцеплена с поверхностью стены, она начинает промерзать и сыреть. Плесень в данном случае начинает возникать на стыках, в углах и внешне очень схожа на черный налет.
2. Слабая вентиляция. Данный фактор больше всего отражается на здоровой среде кухни и ванной, то есть комнатах, в которых влажность всегда повышена. Отсутствует система кондиционирования воздуха, недостаточно проветривание, плотные пластиковые окна, и, как итог, в углах стен начинает возникать грибок.
3. Грунтовая сырость. Если горизонтальная изоляция установлена неверно, грибок может появиться на стыке полов и стен.
4. Неисправность водопровода. Если в вашем водопроводе появилась неисправности и начали течь трубы, грибок начнет распространяться с высокой скоростью. Если не решить эту проблему на начальных этапах, это может стоить хозяевам серьезного ремонта.
5. Протекание крыши. Если на улице тепло, но данный фактор не страшен, но первые же серьезные осадки могут образоваться обширные потеки, которые через некоторое время превратятся в черную плесень. Зимой такие утечки чреваты тем, что замерзшая вода может остаться в штукатурке.
6. Недостаточное отопление в помещении. Если ваша квартира или отдельные комнаты в ней плохо или вообще не отапливаются, она начинает сыреть и проявляется грибок.
Каждая из вышеперечисленных причин появления плесени становится следствием повышенной влажности в помещении. Давайте разберемся, как же от нее избавиться.
Как избавиться от плесени на стенах в квартире: народные средства
Если плесень в вашей квартире находится на начальном этапе развития необязательно использовать химию, можно обойтись и народными средствами.
Масло чайного дерева – одно из самых эффективных средств борьбы с плесенью. У него достаточно резкий аромат, но за это можно не беспокоиться, очень скоро он уйдет. Это масло имеет отличные антибактериальные и противогрибковые свойства, и, помимо уничтожения абсолютно всех видов плесени, оно также помогает вылечить педикулез, перхоть и грибок на ногтях. Поэтому флакончик такого масла обязательно должен присутствовать в вашем доме. Для избавления от плесени применить следующий рецепт: берем 1 ч. л. масла и 1 ч. л воды, наливаем смесь в пульверизатор, взбалтываем и распыляем на зараженные места.
Также достаточно эффективным средством в борьбе с плесенью на стенах является обыкновенный уксус. Он не содержит токсинов и его можно назвать безопасным альтернативным вариантом химии. Как показали последние исследования, даже 5% раствора уксуса будет достаточно, чтобы уничтожить 99% бактерий и 80% вирусов. Итак, берем пульверизатор и наливаем в него 5% уксус. При первых же признаках возникновения грибка на стенах тут же опрыскиваем зараженные зоны. Если вас пугает запах, в состав можно добавить несколько капель эфирного масла, либо еще лучше – масла лаванды.
Еще одним экзотическим, но не менее эффективным средством борьбы с плесенью является экстракт семян грейпфрута. Приобрести их можно в интернете или в магазине здорового питания. Чтобы приготовить раствор, нам нужно смешать 20 капель экстракта и 2 стакана холодной воды. Смешиваем компоненты в пульверизаторе и распыляем на зараженные места.
Как избавиться от плесени на стенах в квартире: химия
Если же плесень в вашей квартире распространяется очень быстро, и вы ничего не можете с ней поделать, можно воспользоваться химическими средствами. Каждый из способов, перечисленных ниже, является достаточно токсичным, поэтому работать с ними нужно очень аккуратно, некоторые из них способны нанести вред не только покрытию, но и самому человеку.
1. Отбеливатель. Берем 1 стакан хлорной извести и разводим в 1 л воды. Отбеливатель прекрасно очищает все поверхности за исключением пористых материалов. Еще одним недостатком такого способа является агрессивная химическая реакция отбеливателя, он способен испортить расцветку вашего ковра, оставляя в нем токсичные пары.
2. Бура. Данный вариант отлично очищает твердые поверхности, к тому же он не выделяет никаких токсичных газов, но на мягких поверхностях вроде ковра он совершенно неэффективен.
3. Аммиак. Готовим раствор, состоящий из аммиака и воды в соотношении 1 к 1. Данный раствор не стоит мешать с отбеливателем, так как от этого появятся токсичные пары. Заливаем раствор в пульверизатор и распыляем его на зараженные зоны. После распыления раствор следует оставить на поверхности на несколько часов, после чего смыть.
4. Перекись водорода. Заливаем 3% перекись водорода в пульверизатор, распыляем его на зараженные зоны и оставляем на 10–15 минут, после чего смываем. Несмотря на то, что данный вариант принято считать альтернативным вариантом отбеливателя, он также способен подпортить некоторые поверхности.
Как избавиться от плесени на стенах в квартире, предотвратить её появление
Не забывайте, что предотвратить возникновение плесени на стенах куда проще, чем с ней бороться. Для этого нужно соблюдать ряд несложных правил:
как можно чаще проветривайте все комнаты, включая кухню и ванную;
белье нужно сушить на балконе или улице, но ни в коем случае не в ванной;
следите, чтобы канализация и краны всегда находились в исправном состоянии;
не забывайте днем открывать шторы во всех комнатах;
установите вентиляция в ванной и кухне;
проводите отопление всех комнат во избежание переохлаждения стен;
дверь в ванную всегда нужно оставлять открытой;
не выращивайте герань и фиалки, в этих цветах очень любит заводиться и размножаться грибок;
не устанавливайте мебель слишком близко к стенам, чтобы воздух мог свободно циркулировать;
во время проведения ремонтных работ применяйте влагоустойчивые материалы.
Плесень – очень опасный и неприятный враг, но бороться с ним можно и нужно, и чем раньше вы начнете это делать, тем проще вам будет избавиться от грибка на стенах.
zhenskoe-mnenie.ru